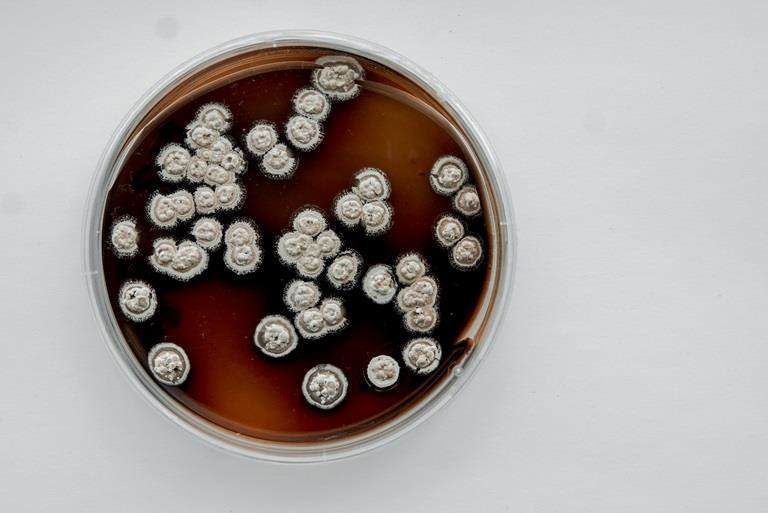
ペトリ皿

クローダの事例研究(ケーススタディー)
クローダの事例研究(ケーススタディー)をご覧ください。
事例研究(ケーススタディー)一覧

遺伝資源への公平なアクセスと利益配分、生物多様性の保全のために | Brogota Project第3版の制作を支援
当社は第15回生物多様性条約締約国会議(COP15)のサイドイベントを通じ、Brogota Project第3版の制作を支援しました。

Flue2Chemプロジェクト
産業界全体として気候非常事態に対処するための新たな共同の取り組みに、イノベートUK(Innovate UK)の助成を受けたFlue2Chemプロジェクトがあります。このプロジェクトの目的は、英国のサプライチェーンを利用してCO2からアルコキシル化界面活性剤を製造するのは経済的にも技術的にも実現可能であるということを立証してみせることにあります。

イギリスの製造施設のネットゼロへのロードマップ | 「未来の産業」(Industry of the Future)プログラム
当社はイギリス政府ビジネス・エネルギー・産業戦略省の「未来の産業」(Industry of the Future)プログラムの一環として、2050年までのネットゼロ達成のロードマップをいち早く策定した製造施設の1つです。

炭素削減カスタマーアワード
当社はシンジェンタとのパートナーシップにより、同社が掲げるビジネスとサステナビリティの目標にかなった革新的で持続可能な原料を提供しています。生産地、組成および環境への影響に関して透明性を高めるとともに、使用時の優れた持続可能性を保証しています。

持続可能性連動型のリボルビング信用枠(RCF)
当社は2019年、英国の多くの株式を上場している大手企業に先駆けて、持続可能性をリボルビング信用枠(RCF)の指標の1つに盛り込みました。2030年までに気候にプラスの貢献をする(Climate Positive)という当社のコミットメントに合わせた、7年間の合意を目標としています。

人に優しい安全対策で業績も向上 | Me Saksham
インドのターネー(Thane)にある当社の製造施設で、長年の課題であるインフラおよび業務上の問題を解決するための取り組みの強化が、試験的なヒューマンパフォーマンスプログラムのもとで進められています。

ASD Kaleka Mosaik Initiativeインパクト基金 | Tides Foundationとのパートナーシップ
私たちは、Tides Foundationとのパートナーシップで創設された初のASDインパクト基金に協力しています。

クロップケア事業のオーガニックグロースのための投資 | 2022年ブラジルにAtlox 4913TMの生産ラインを増強
Atlox 4913TMは複雑な作物用製剤の安定した分散液を得られることで、お客様から高い評価を受けています。有効成分を均一に分布させつつ製剤の崩壊を防止できます。

ライフサイクルアセスメント
当社はライフサイクルアセスメント(LCA)のメリットを実現したいとお考えのお客様をサポートするため、2022年にはLCA Centre of Excellenceの開設に着手しました。さまざまな分野のポートフォリオについて、リスク・ベネフィット評価のお手伝いをしております。

心血管疾患の予防に役立つ薬物送達システムを供給
核酸医薬は画期的な次世代の医薬品クラスであり、各種のエキサイティングな用途が期待されています。例えば遺伝子編集により、疾患の治療のために患者の遺伝物質に修飾を加えることができます。

妥協せず、持続可能なChromaPur | マイクロビーズの代替品
人工の小さいプラスチック粒子であるマイクロビーズは化粧品やパーソナルケア製品に広く使用されており、化粧品のベストセラー10ブランドの製品中、87%の製品にこのマイクロプラスチックが含まれているという調査結果も得られています。

アマゾンのアグロフォレストリー
クローダ財団はInstituto Amazonasのアグロフォレストリー・プロジェクトを支援しています。このプロジェクトは、先住民部族の伝統的な農耕方式を復活させることにより、食糧安全保障を強化し、彼らの文化遺産と環境を守ることを目的としています。
グループの力を結集して天然有効成分の開発を加速 |化粧品業界の合成成分を持続可能な代替品で置き換える
化粧品業界は合成成分を持続可能な代替品で置き換える方向へと動いており、天然由来の有効成分の需要が高まっています。
クローダの事例研究(ケーススタディー)